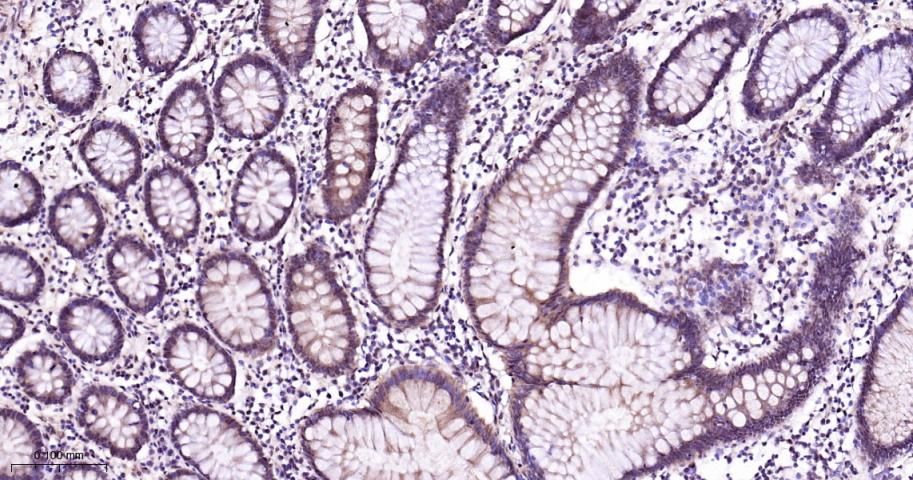
产品细节图片3

相关产品推荐更多 >
万千商家帮你免费找货
0 人在求购买到急需产品
- 详细信息
- 文献和实验
- 技术资料
- 应用范围:
产品信息以Bioss网站为准
- 规格:
50ul/100ul/200ul
| 规格: | 50ul | 产品价格: | ¥1180.0 |
|---|---|---|---|
| 规格: | 100ul | 产品价格: | ¥1980.0 |
| 规格: | 200ul | 产品价格: | ¥2800.0 |
| 产品编号 | bs-28027R |
| 英文名称 | P38 MAPK/ MAPK14 Rabbit pAb |
| 中文名称 | 丝裂原活化蛋白激酶p38α抗体 |
| 英文别名 | CSAID Binding Protein 1; CSAID binding protein; CSAID-binding protein; Csaids binding protein; CSBP 1; CSBP 2; CSBP; CSBP1; CSBP2; CSPB 1; CSPB1; Cytokine suppressive anti inflammatory drug binding protein; Cytokine suppressive anti-inflammatory drug-binding protein; EXIP; MAP kinase 14; MAP kinase MXI2; MAP kinase p38 alpha; MAPK 14; MAPK14; MAX interacting protein 2; MAX-interacting protein 2; Mitogen Activated Protein Kinase 14; Mitogen activated protein kinase p38 alpha; Mitogen-activated protein kinase 14; Mitogen-activated protein kinase p38 alpha; MK14_HUMAN; Mxi 2; Mxi2; p38 ALPHA; p38; p38 MAP kinase; p38 MAPK; p38/MAPK; p38 mitogen activated protein kinase; p38ALPHA; p38alpha Exip; PRKM14; PRKM15; RK; SAPK 2A; SAPK2A; Stress Activated Protein Kinase 2A. |
| 产品应用 | IHC-P=1:100-500, IHC-F=1:100-500, IF=1:100-500 Not yet tested in other applications. |
| 交叉反应 | Human, Mouse, Rat |
| 抗体来源 | Rabbit |
| 免疫原 | KLH conjugated synthetic peptide derived from human P38 MAPK/ MAPK14 |
| 亚型 | IgG |
| 性状 | Liquid |
| 纯化方法 | affinity purified by Protein A |
| 克隆类型 | Polyclonal |
| 理论分子量 | 41 kDa |
| 浓度 | 1mg/ml |
| 储存液 | 0.01M TBS (pH7.4) with 1% BSA, 0.02% Proclin300 and 50% Glycerol. |
| 研究领域 | Cancer > Signal transduction > Protein phosphorylation > Serine/threonine kinases > MAPK pathway Immunology > Innate Immunity > TLR Signaling Kits/ Lysates/ Other > Kits > Cell Signaling Kits > Other Cell Signaling Kits Signal Transduction > Protein Phosphorylation > Ser / Thr Kinases > MAPK Pathway |
| 亚基 | Binds to a kinase interaction motif within the protein tyrosine phosphatase, PTPRR (By similarity). This interaction retains MAPK14 in the cytoplasm and prevents nuclear accumulation. Interacts with SPAG9 and GADD45A. Interacts with CDC25B, CDC25C, DUSP1, DUSP10, DUSP16, NP60, FAM48A and TAB1. Interacts with casein kinase II subunits CSNK2A1 and CSNK2B. |
| 亚细胞定位 | Cytoplasm. Nucleus. |
| 组织特异性 | Brain, heart, placenta, pancreas and skeletal muscle. Expressed to a lesser extent in lung, liver and kidney. |
| 翻译后修饰 | Dually phosphorylated on Thr-180 and Tyr-182 by the MAP2Ks MAP2K3/MKK3, MAP2K4/MKK4 and MAP2K6/MKK6 in response to inflammatory citokines, environmental stress or growth factors, which a ctivates the enzyme. Dual phosphorylation can also be mediated by TAB1-mediated autophosphorylation. TCR engagement in T-cells also leads to Tyr-323 phosphorylation by ZAP70. Dephosphorylated and inactivated by DUPS1, DUSP10 and DUSP16. Acetylated at Lys-53 and Lys-152 by KAT2B and EP300. Acetylation at Lys-53 increases the affinity for ATP and enhances kinase activity. Lys-53 and Lys-152 are deacetylated by HDAC3. Ubiquitinated. Ubiquitination leads to degradation by the proteasome pathway. |
| 相似性 | Belongs to the protein kinase superfamily. CMGC Ser/Thr protein kinase family. MAP kinase subfamily. Contains 1 protein kinase domain. |
| 功能 | Serine/threonine kinase which acts as an essential component of the MAP kinase signal transduction pathway. MAPK14 is one of the four p38 MAPKs which play an important role in the cascades of cellular responses evoked by extracellular stimuli such as proinflammatory cytokines or physical stress leading to direct activation of transcription factors. Accordingly, p38 MAPKs phosphorylate a broad range of proteins and it has been estimated that they may have approximately 200 to 300 substrates each. Some of the targets are downstream kinases which are activated through phosphorylation and further phosphorylate additional targets. RPS6KA5/MSK1 and RPS6KA4/MSK2 can directly phosphorylate and activate transcription factors such as CREB1, ATF1, the NF-kappa-B isoform RELA/NFKB3, STAT1 and STAT3, but can also phosphorylate histone H3 and the nucleosomal protein HMGN1. RPS6KA5/MSK1 and RPS6KA4/MSK2 play important roles in the rapid induction of immediate-early genes in response to stress or mitogenic stimuli, either by inducing chromatin remodeling or by recruiting the transcription machinery. On the other hand, two other kinase targets, MAPKAPK2/MK2 and MAPKAPK3/MK3, participate in the control of gene expression mostly at the post-transcriptional level, by phosphorylating ZFP36 (tristetraprolin) and ELAVL1, and by regulating EEF2K, which is important for the elongation of mRNA during translation. MKNK1/MNK1 and MKNK2/MNK2, two other kinases activated by p38 MAPKs, regulate protein synthesis by phosphorylating the initiation factor EIF4E2. MAPK14 interacts also with casein kinase II, leading to its activation through autophosphorylation and further phosphorylation of TP53/p53. In the cytoplasm, the p38 MAPK pathway is an important regulator of protein turnover. For example, CFLAR is an inhibitor of TNF-induced apoptosis whose proteasome-mediated degradation is regulated by p38 MAPK phosphorylation. In a similar way, MAPK14 phosphorylates the ubiquitin ligase SIAH2, regulating its activity towards EGLN3. MAPK14 may also inhibit the lysosomal degradation pathway of autophagy by interfering with the intracellular trafficking of the transmembrane protein ATG9. Another function of MAPK14 is to regulate the endocytosis of membrane receptors by different mechanisms that impinge on the small GTPase RAB5A. In addition, clathrin-mediated EGFR internalization induced by inflammatory cytokines and UV irradiation depends on MAPK14-mediated phosphorylation of EGFR itself as well as of RAB5A effectors. Ectodomain shedding of transmembrane proteins is regulated by p38 MAPKs as well. In response to inflammatory stimuli, p38 MAPKs phosphorylate the membrane-associated metalloprotease ADAM17. Such phosphorylation is required for ADAM17-mediated ectodomain shedding of TGF-alpha family ligands, which results in the activation of EGFR signaling and cell proliferation. Another p38 MAPK substrate is FGFR1. FGFR1 can be translocated from the extracellular space into the cytosol and nucleus of target cells, and regulates processes such as rRNA synthesis and cell growth. FGFR1 translocation requires p38 MAPK activation. In the nucleus, many transcription factors are phosphorylated and activated by p38 MAPKs in response to different stimuli. Classical examples include ATF1, ATF2, ATF6, ELK1, PTPRH, DDIT3, TP53/p53 and MEF2C and MEF2A. The p38 MAPKs are emerging as important modulators of gene expression by regulating chromatin modifiers and remodelers. The promoters of several genes involved in the inflammatory response, such as IL6, IL8 and IL12B, display a p38 MAPK-dependent enrichment of histone H3 phosphorylation on 'Ser-10' (H3S10ph) in LPS-stimulated myeloid cells. This phosphorylation enhances the accessibility of the cryptic NF-kappa-B-binding sites marking promoters for increased NF-kappa-B recruitment. Phosphorylates CDC25B and CDC25C which is required for binding to 14-3-3 proteins and leads to initiation of a G2 delay after ultraviolet radiation. Phosphorylates TIAR following DNA damage, releasing TIAR from GADD45A mRNA and preventing mRNA degradation. The p38 MAPKs may also have kinase-independent roles, which are thought to be due to the binding to targets in the absence of phosphorylation. Protein O-Glc-N-acylation catalyzed by the OGT is regulated by MAPK14, and, although OGT does not seem to be phosphorylated by MAPK14, their interaction increases upon MAPK14 activation induced by glucose deprivation. This interaction may regulate OGT activity by recruiting it to specific targets such as neurofilament H, stimulating its O-Glc-N-acylation. Required in mid-fetal development for the growth of embryo-derived blood vessels in the labyrinth layer of the placenta. Also plays an essential role in developmental and stress-induced erythropoiesis, through regulation of EPO gene expression. Isoform MXI2 activation is stimulated by mitogens and oxidative stress and only poorly phosphorylates ELK1 and ATF2. Isoform EXIP may play a role in the early onset of apoptosis. Phosphorylates S100A9 at 'Thr-113'. |
| 保存条件 | Shipped at 4℃. Store at -20℃ for one year. Avoid repeated freeze/thaw cycles. |
| 注意事项 | This product as supplied is intended for research use only, not for use in human, therapeutic or diagnostic applications. |
| 背景资料 | The protein encoded by this gene is a member of the MAP kinase family. MAP kinases act as an integration point for multiple biochemical signals, and are involved in a wide variety of cellular processes such as proliferation, differentiation, transcription regulation and development. This kinase is activated by various environmental stresses and proinflammatory cytokines. The activation requires its phosphorylation by MAP kinase kinases(MKKs), or its autophosphorylation triggered by the interaction of MAP3K7IP1/TAB1 protein with this kinase. The substrates of this kinase include transcription regulator ATF2, MEF2C, and MAX, cell cycle regulator CDC25B, and tumor suppressor p53, which suggest the roles of this kinase in stress related transcription and cell cycle regulation, as well as in genotoxic stress response. Four alternatively spliced transcript variants of this gene encoding distinct isoforms have been reported. |
| 应用 | 推荐稀释比例 |
| {IHC-P} | {1:100-500} |
| {IHC-F} | {1:100-500} |
| {IF} | {1:100-500} |

风险提示:丁香通仅作为第三方平台,为商家信息发布提供平台空间。用户咨询产品时请注意保护个人信息及财产安全,合理判断,谨慎选购商品,商家和用户对交易行为负责。对于医疗器械类产品,请先查证核实企业经营资质和医疗器械产品注册证情况。
文献和实验[IF={{ 4.868 }}] {Chi Q et al. Hydrogen Sulfide Gas Exposure Induces Necroptosis and Promotes Inflammation through the MAPK/NF-κB Pathway in Broiler Spleen. Oxid Med Cell Longev. 2019 Jul 31;2019:8061823.} {WB} {broiler}
[IF={{ 4.734 }}] {Liu F et al. Anticancer targets and mechanisms of calycosin to treat nasopharyngeal carcinoma. Biofactors. 2020 Jul;46(4):675-684.} {IF} {Human/Mouse}
[IF={{ 4.2 }}] {Jiajun Han. et al. Xuefu Zhuyu Decoction improves hyperlipidemia through the MAPK/NF-κB and MAPK/PPARα/CPT-1A signaling pathway. FASEB J. 2025 Jan;39(2):e70363} {WB} {Rat}
[IF={{ 4.014 }}] {Manman Shen. et al. Effects of quercetin on granulosa cells from pre-hierarchical follicles by modulating MAPK signaling pathway in chicken. POULTRY SCIENCE. 2023 Apr;:102736} {WB} {Chicken}
[IF={{ 3.8 }}] {Yuquan Guo. et al. Revealing the Mechanism: The Influence of Baicalin on M1/M2 and Th1/Th2 Imbalances in Mycoplasma gallisepticum Infection. POULTRY SCI. 2024 Jul;:104145} {WB} {Chicken}
secondary antibody were purchased from GIBCO-BRL. Phosphospecific rabbit polyclonal antibodies against 180Thr and 182Tyr dual-phosphorylated p38, against total p38 (phosphorylation state independent), against 204Tyr-phosphorylated ERK1/2 and against total
Functional Assays on High‐Content Protein Microarrays
Kinase blocking buffer: phosphate‐buffered saline (PBS) containing 1% (w/v) BSA MAPK14/p38γ protein kinase (Invitrogen, cat. no. PV3304
secondary antibody review -- data from 99 publications
data
技术资料暂无技术资料 索取技术资料









